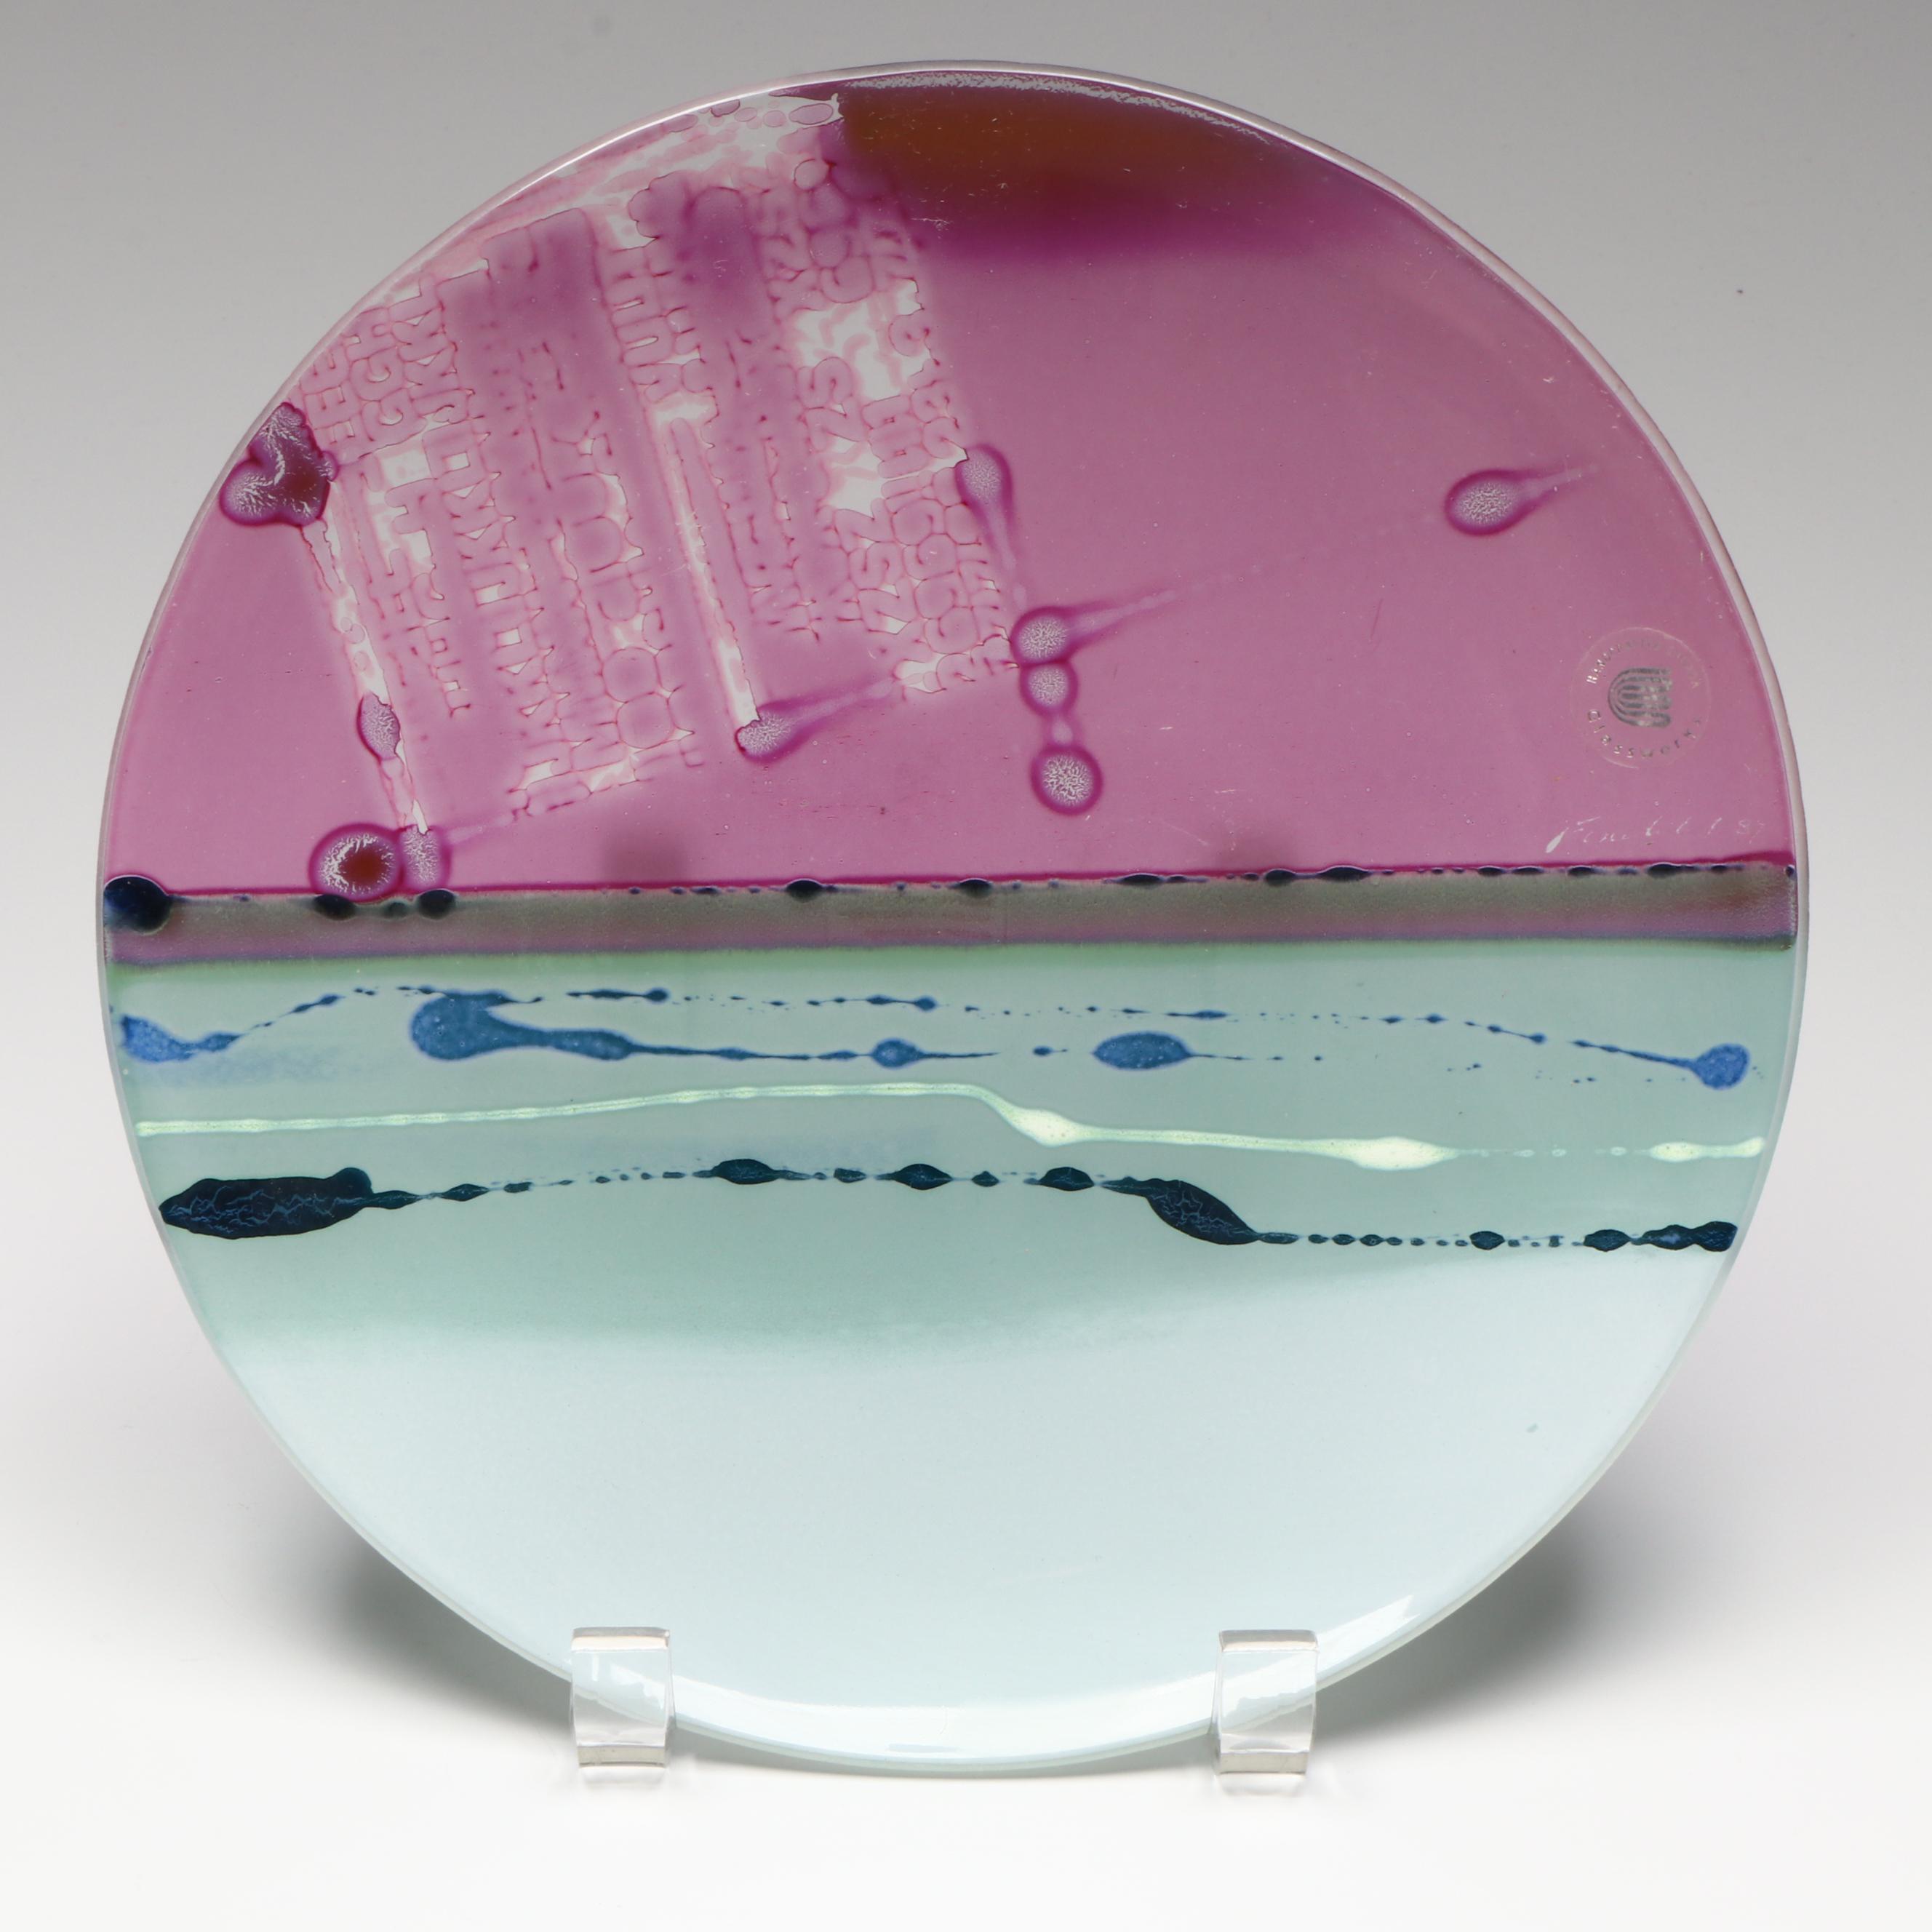
Canada Glassworks Art Glass Charger and Decorative Plate

View all items from Marvelously Modern sale
Canada Glassworks Art Glass Charger and Decorative Plate
Item Details
| Type | Charger, Decorative Plate |
| Brand | Canada Glassworks |
| Materials | Glass |
| Marks | Label, Pictorial Maker’s Mark, Maker’s Mark |
| Origin | Canada |
Condition
- scratches; residue; surface irregularities and wear.
Dimensions
16.75" W x 1.5" H x 16.75" D
- measures larger plate..
Item #
ITMGQ76800